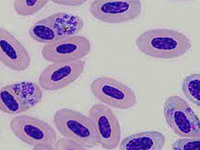

|
Enfermedades infecciosas causan dos de cada tres muertes de menores de 5 años
 Miércoles, 12/5/2010 - 18:14
Miércoles, 12/5/2010 - 18:14
Casi la mitad de los fallecimientos de menores de cinco años se concentran sólo en cinco países: India, Nigeria, la República Democrática del Congo, Pakistán y China. Mientras, los países con ingresos elevados registran un pequeño porcentaje de estas mujeres, cercano al 1%.
Leer más...
|
|
Un hongo tropical mortal se extiende por el noroeste de EEUU
 Lunes, 3/5/2010 - 14:25
Lunes, 3/5/2010 - 14:25
El hongo 'Cryptococcus gattii', ha infectado a decenas de personas y animales -en los que se incluyen gatos, perros o delfines- en los últimos cinco años en los estados de Washington y Oregón.
Leer más...
|
|
Bill Gates preocupado por la excesiva financiación contra el cambio climático en los países en desarrollo
 Viernes, 16/4/2010 - 18:29
Viernes, 16/4/2010 - 18:29
Bill Gates: 'Si tan sólo un 1% de aquellos 100.000 millones de dólares se consiguiesen recortando los fondos para vacunaciones (en el tercer mundo), entonces 700.000 niños más morirán de enfermedades que son curables'.
Leer más...
|
|
¿Y qué ocurrió con la gripe porcina?
 Sábado, 16/1/2010 - 20:39
Sábado, 16/1/2010 - 20:39
Cuando la Organización Mundial de la Salud (declaró en junio de 2009 que la gripe porcina era una pandemia, los científicos advirtieron que podría ser la peor amenaza de salud pública de los últimos cuarenta años.
Leer más...
|
|
Ola de frío en Cuba mata a 26 en hospital psiquiátrico
 Viernes, 15/1/2010 - 19:52
Viernes, 15/1/2010 - 19:52
Veinte y seis pacientes en el hospital más grande de Cuba para enfermos mentales murió esta semana, durante una ola de frío, el gobierno dijo el viernes.
Leer más...
|
|
Más de 10.000 muertos por gripe H1 en el mundo
 Lunes, 21/12/2009 - 16:22
Lunes, 21/12/2009 - 16:22
El número de fallecimientos provocados por la gripe H1N1 superó el umbral de los 10.000 en el mundo desde su aparición en la primavera (boreal), según el último balance publicado por la Organización Mundial de la Salud (OMS).
Leer más...
|
|
El uso masivo de veneno contra los topillos pudo desencadenar la tularemia
 Martes, 1/12/2009 - 22:17
Martes, 1/12/2009 - 22:17
Un estudio del Consejo Superior de Investigaciones Científicas (CSIC) y de la Universidad de Valladolid (UVA) publicado en 'Science of the Total Environment' señala que el uso masivo de venenos para controlar la plaga de topillos de 2007 pudo favorecer la propagación de la tularemia.
Leer más...
|
|
Expertos rastrean vínculo enfermedades con 'mapa genético' chino
 Sábado, 28/11/2009 - 16:15
Sábado, 28/11/2009 - 16:15
Un extenso análisis de los genes de 8.200 chinos de diferentes etnias reveló sutiles diferencias entre habitantes del norte y del sur del país, e incluso entre grupos con diferentes dialectos.
Leer más...
|
|
Mal de Chagas causa 14 mil muertes por año
 Lunes, 9/11/2009 - 6:57
Lunes, 9/11/2009 - 6:57
El insecto que transmite esta enfermedad al estar sano puede infectarse si pica a una persona que tenga este padecimiento, y así adquirir la capacidad de seguir propagando este parásito.
Leer más...
|
|
Descubren 44 linajes nuevos de parásitos que originan la malaria en aves
Sábado, 10/10/2009 - 11:51
Sábado, 10/10/2009 - 11:51
Cuarenta y cuatro nuevos linajes de parásitos causantes de la malaria en aves silvestres han sido descubiertos por científicos de la Universidad Europea Miguel de Cervantes (UEMC), en el marco de una investigación genética sobre la enfermedad que afecta a millones de ejemplares en todo el planeta.
Leer más...
|
|
Modelos predictivos ayudan a combatir el dengue en Latinoamérica
 Viernes, 2/10/2009 - 0:5
Viernes, 2/10/2009 - 0:5
Investigadores y epidemiólogos apuestan a modelos matemáticos predictivos, al control integrado de los vectores y a la intevención comunitaria, como una estratregia de Salud en el continente americano para enfrentar al Aedes aegyti, el mosquito transmisor del dengue.
Leer más...
|
|
Descubren un mecanismo molecular que facilita a los virus de la gripe aviar su paso a los humanos
 Jueves, 1/10/2009 - 23:0
Jueves, 1/10/2009 - 23:0
Los científicos descubrieron que algunos virus aviares podrían establecer un punto de apoyo en los humanos de forma más fácil que otras variantes debido a una habilidad latente para unirse a los receptores humanos.
Leer más...
|
|
Hay pocas probabilidades que H1N1 mute a 'superbacteria'
 Jueves, 3/9/2009 - 8:33
Jueves, 3/9/2009 - 8:33
El nuevo virus de la influenza H1N1 parece dominar a los de la gripe estacional, lo que lo vuelve menos propenso a mezclarse con otras cepas circulantes y convertirse en una 'superbacteria como algunos temían, dijeron el martes investigadores estadounidenses.
Leer más...
|
|
Identificada una nueva cepa del VIH que deriva de los gorilas
 Miércoles, 5/8/2009 - 10:2
Miércoles, 5/8/2009 - 10:2
Los expertos esperan que pueda tratarse con los mismos fármacos antivirales
Leer más...
|
|
4 |







